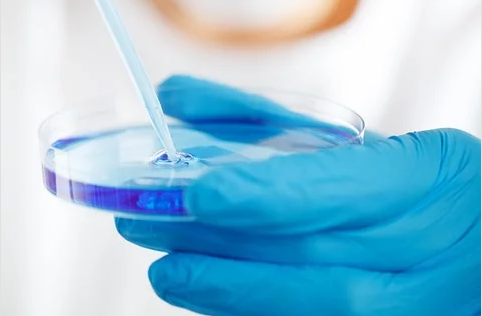
analisi liquido azzurro

NOVARA- 14-04-2020-- Il senatore di Fratelli d’Italia,
Gaetano Nastri, in un comunicato stampa, spiega che i medici di base vanno sostenuti per loro sacrificio: " “In un momento così difficile per la nostra Nazione il mio ringraziamento va a chi in prima fila si batte contro il Covid-19. Penso ai tantissimi medici di base che sono impegnati nel fronteggiare questa tremenda emergenza sanitaria, molto spesso senza i necessari dispositivi di sicurezza che il governo ancora non ha messo a loro disposizione. Centinaia sono i medici rimasti vittime di un nemico invisibile ma pericolosissimo, che il governo all’inizio di questa tragedia ha sottovalutato e tentato di minimizzare. I medici di base bisogna sostenerli sempre nel loro quotidiano impegno contro il Covid-19, ma anche per il quotidiano impegno a tutela della salute di tutti gli italiani. Il mio plauso, quindi, va a tutti i medici di base italiani che senza sosta svolgono la loro missione”.


